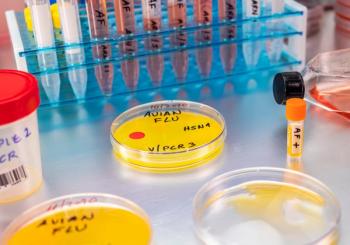

Infectious Disease
Latest News
Latest Videos
CME Content
More News

Searching for the clinical and economic impacts, researchers explored the implications of pharmacist-led anti-infective consultations.

FDA approves Biktarvy for HIV treatment in patients not virologically suppressed, enhancing options for those restarting antiretroviral therapy.

The decision makes the therapy the first and only twice-yearly option available in the United States for PrEP.

The therapy is the first and only oral direct acting antiviral approved by the FDA for HCV infection.

The therapy is the first and only RSV preventative option using the same dose regardless of patient weight.

Building trust with patients through fact-based information could help boost vaccination rates to the desirable coverage.

Pharmacy team members can help patients prepare for upcoming travels, ensuring they are up to date with the recommended vaccines for their locations.

Pharmacists play a critical role in vaccination and education for patients about the evolving infectious disease landscape.

During Viral Hepatitis Awareness Month, Jeff Goad, PharmD, MPH, joined Over the Counter to discuss hepatitis vaccines and the common trends pharmacists in this space should keep in mind.

Approximately 67% of adults in the US know that vaccines do not cause autism in children, declining significantly from 74% in 2021.

Jeff Goad, PharmD, MPH, discusses hesitancy for hepatitis vaccines and the necessary advice pharmacists can utilize to help patients manage these misconceptions.

Jeff Goad, PharmD, MPH, discusses hepatitis viruses and the current vaccination schedules available for patients to stay protected.

The investigators hope to pursue a human vaccine in order to improve upon the already existing vaccines.

A phase 2 study found 95% of patients achieved a sustained virologic response at 12 weeks regardless of treatment adherence.

Global virus and public health experts gathered to assess the need for an enhanced response to the bird flu spreading among humans and animals.

The findings support the need for improved vaccination coverage to prevent the resurgence of previously eliminated infectious diseases in the United States.

In a new survey, approximately one-third of respondents have heard that the MMR vaccine is more dangerous than being infected with the infection.

Crystal Hodge discusses being transparent about adverse effects of the MMR vaccine and educating patients about measles.

Crystal Hodge discusses R naughts and the measures of how contagious measles is.

The recommendation includes patients 12 years and older traveling to a country where there is a chikungunya outbreak or where there is an elevated risk for US travelers.

The FDA approved Penmenvy in February 2025 for use in patients aged 10 to 25 years.

The designation addresses the unmet need for prevention of H5N1, which remains a global health risk, and a phase 1 trial of the vaccine was initiated in November 2024.

Texas reports over 480 cases of measles and 2 measles-related deaths, with 1 including an unvaccinated pediatric patient.
Bird flu cases total 70 US patients as more animals are infected.

The approval expands the flexibility of storing the vaccine to protect against smallpox events or mpox outbreaks.